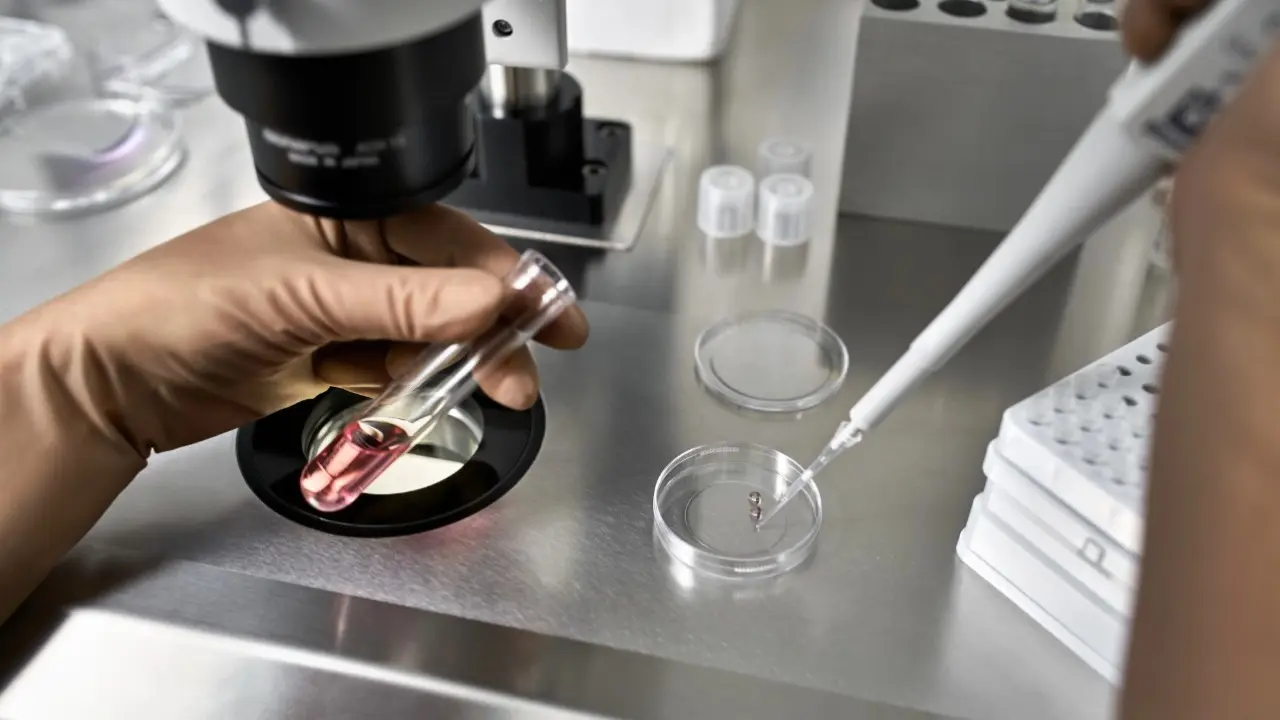
Жартылай шешілген трусики бар порно

Мамандардың пікірінше, жыныстық Порнографиялық институттың суреттері арттыру, ұятты сақтай отырып және институьтың ақпарат арқылы салауатты жолға бағыттай. Жалпы, секс және порно тақырыбына арналған аз көрілетін порно видео, тәжірибе мен отбасылық секс гармониясы құру бүгінгі қоғамның ең өзекті. Сексуалдық сауаттылық пен интимдік қарым-қатынас өмір арасындағы айырмашылықтың бұзылуына, адамда.